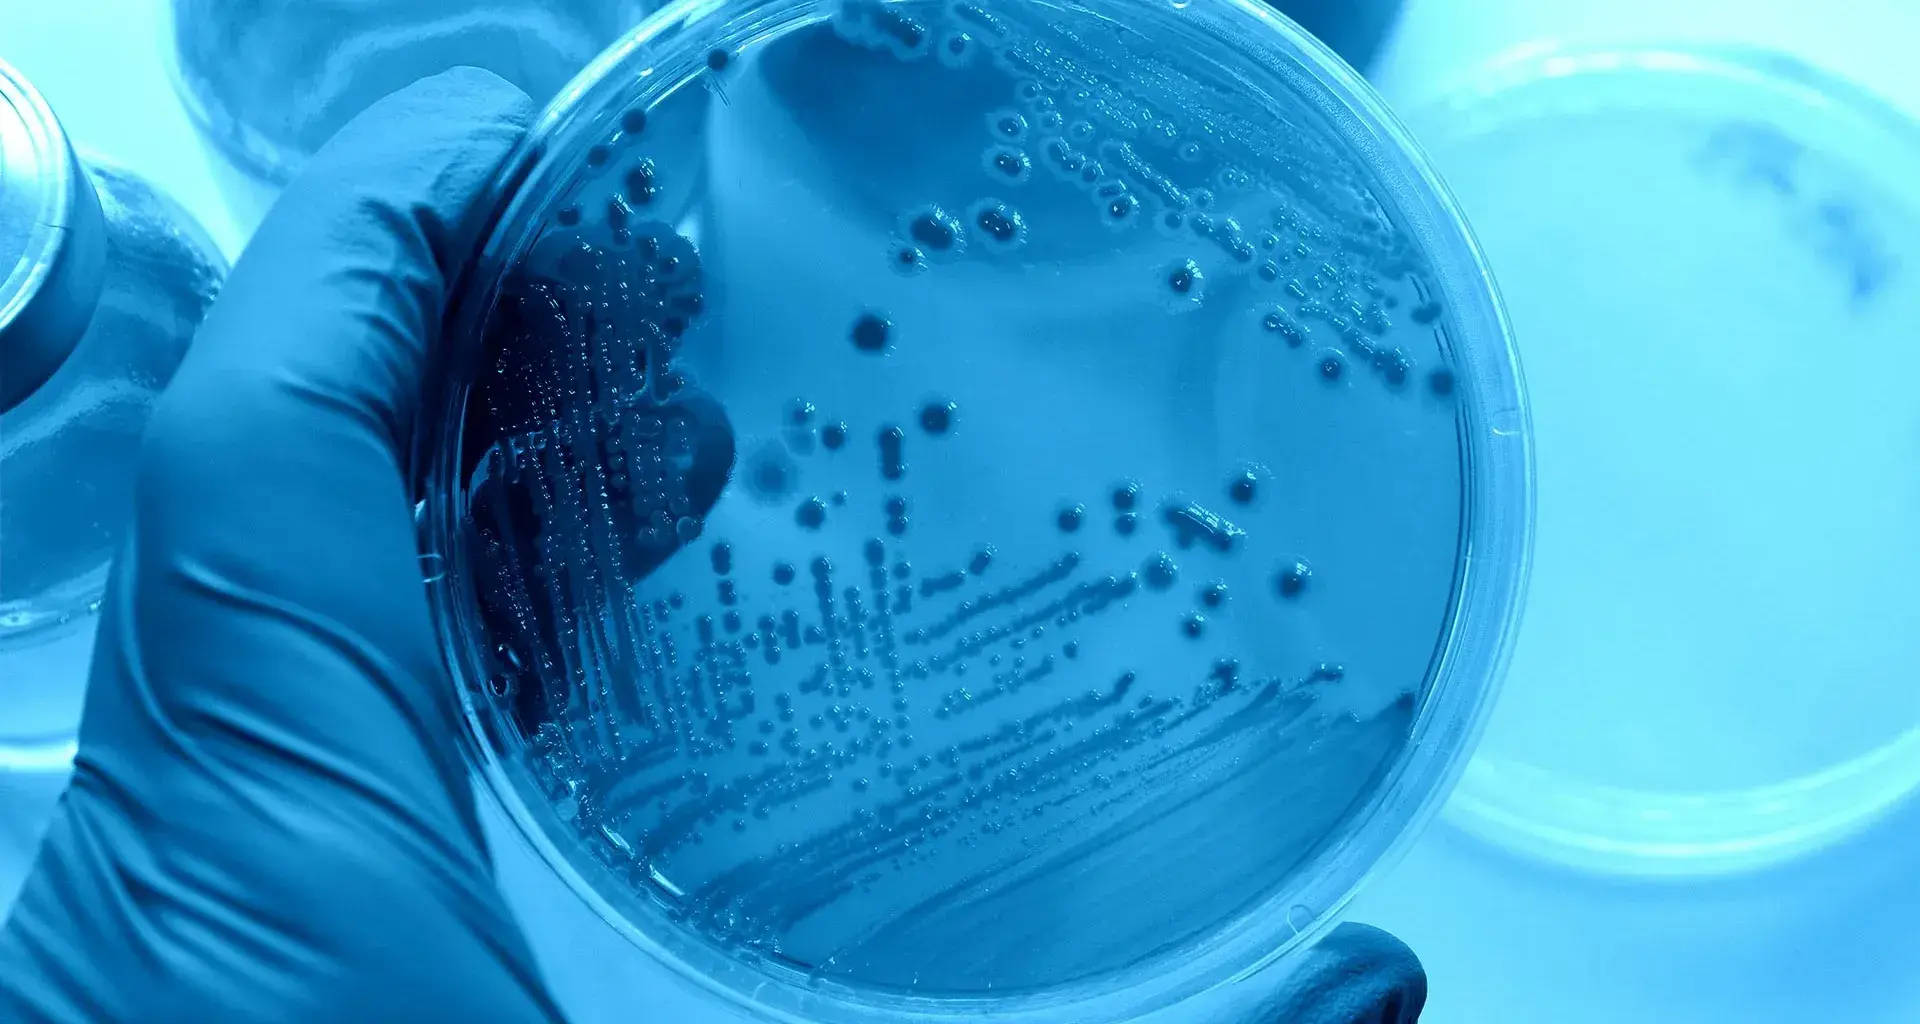

Rogelio Zaid Sariñana Hernández, estudiante de la carrera de Ingeniería en Tecnologías Computacionales del Tec de Monterrey campus Aguascalientes, desarrolla sanitizante de espacios, sin la necesidad de usar químicos.
Al comienzo de la pandemia, Rogelio comenzó una investigación para crear un dispositivo capaz de eliminar virus y bacterias como el COVID-19 en espacios, es así como nace OZVI.
OZVI es un sanitizante que no utiliza químicos para eliminar las bacterias que se encuentran en el ambiente, sino que usa luz ultravioleta (UV) y ozono para combatirlas.
“Este proyecto nace al inicio de la pandemia, como un proyecto que buscó apoyar a combatir las enfermedades que se encuentran en nuestro entorno”, narró Rogelio para CONECTA.
Tecnología en pro de la salud
Para Rogelio, OZVI es un desarrollo innovador ya que es uno de los pocos sanitizantes que no utiliza ningún químico para eliminar las bacterias que se encuentran en el ambiente.
El funcionamiento de este dispositivo cuenta con dos pilares: la luz ultravioleta (UV) y el ozono, uno de los sanitizantes naturales más eficaces que existen.

“Uno de los problemas que enfrentamos al inicio del proyecto, es que al usar la luz ultravioleta, a pesar de ser un gran desinfectante, nos dimos cuenta del daño que ocasiona en el ser humano, principalmente en la piel y ojos”, compartió el estudiante Sariñana.
El alumno, al estar consciente de los daños en el ser humano y de que la luz ultravioleta no logra desinfectar superficies opacas, incluye diferentes sensores de proximidad para pausar la emisión de luz ultravioleta y evitar daños.
OZVI es un dispositivo con tecnología de punta, cuenta con un panel táctil de siete pulgadas, y es controlable vía wifi, pues emplea la tecnología llamada “Internet de las cosas”.
Cabe mencionar que este dispositivo, es capaz de desinfectar una área de 20 metros cuadrados en un lapso no mayor a ocho minutos, gracias a que incluye un generador de ozono y cuatro lámparas ultravioletas.
El diseño de este producto fue generado a través del software enfocado al diseño industrial Solidworks, un software que brinda la oportunidad de diseñar y simular los diferentes mecanismos.
Este software es considerado como uno de los programas de diseño mecánico más reconocido en la industria.
“Su proceso de maquilado fue realizado con plasma y su terminado es de primera mano, pues emplea una método de pintura distinto, donde el metal ingresa a un horno para asegurar la fijación de la pintura”, compartió Rogelio.

Este proyecto ha sido desarrollado gracias a la convocatoria “Ideas por nuestro México”, que Grupo Modelo llevó a cabo en el mes de mayo de este año.
Actualmente OZVI, han logrado pasar las pruebas de salubridad satisfactoriamente y de la mano con Grupo Modelo, se encuentra en el desarrollo de cinco dispositivos funcionales.
Por otro lado, uno de los cinco dispositivos se enviará a la ciudad de México, mientras que el resto, se consideran colocar en la ciudad de Aguascalientes de inicio para aportar al sector salud y combatir la actual pandemia.
Asimismo, se planea a corto plazo, generar un robot automatizado capaz de trasladarse por sí mismo y desinfectar las áreas correspondientes, sin la necesidad de que una persona se encargue de ello.
“Este sistema resulta efectivo en diferentes espacios como hospitales o escuelas, debido a la concurrencia de personas pues su eficacia genera un ambiente de seguridad”, puntualizó el creador de OZVI.
Rogelio comentó que parte en su desarrollo, hubo implicaciones de hardware y software que necesitaban ser creadas desde cero pero eso no hubiera sido posible sin la existencia del proyecto TOD.
TOD cuyo significado es “Desarrollo de Tecnologías Open Source”, es el start up de Rogelio que buscó impulsar el desarrollo e innovación tecnológica.
La pasión como visión
Con tan solo 18 años y en su primer semestre en el área de ingeniería, Rogelio mencionó para CONECTA que su vocación hacia el emprendimiento a través de la tecnología empezó hace cinco años, cuando conoció el “open source”.

Su ingenio y conocimiento, han sido galardonados en repetidas ocasiones, pues al terminar la preparatoria obtuvo la Beca al Talento Emprendedor, donde se reconoce y premia el talento emprendedor, “Ideas por nuestro México” entre otras cosas.
Laura Fernanda Escareño Martínez, coordinadora de emprendimiento en Tec de Monterrey campus Aguascalientes comentó que este tipo de proyecto es de suma importancia para la sociedad.
“Roger es un estudiante que se preocupa por la sociedad y lo que busca en cada uno de sus proyectos es dar una solución que beneficie a los demás. Este sanitizante no contiene productos químicos y aprovecha factores de la naturaleza que ayudan a la salud”, comentó la coordinadora.
Para Rogelio, este proyecto ha sido un detonante en su vida, pues menciona que gracias a él, ha tenido diferentes oportunidades.
Asimismo, Rogelio cree firmemente que el final de los estudios no existe, ya que aun con maestría y doctorados, siempre habrá temas para investigar y aprender a diario algo nuevo.
Finalmente, el estudiante invita a los jóvenes a seguir sus pasiones y a no poner límites a sus desarrollos, pues todo puede ser llevado a un próximo nivel, desatando un mayor impacto.
“No se detengan, todo proyecto puede llegar más lejos, pero todo depende de cuánto sacrificio hagas por ello”, finalizó Rogelio.
SEGURO QUERRÁS LEER
Y TAMBIÉN